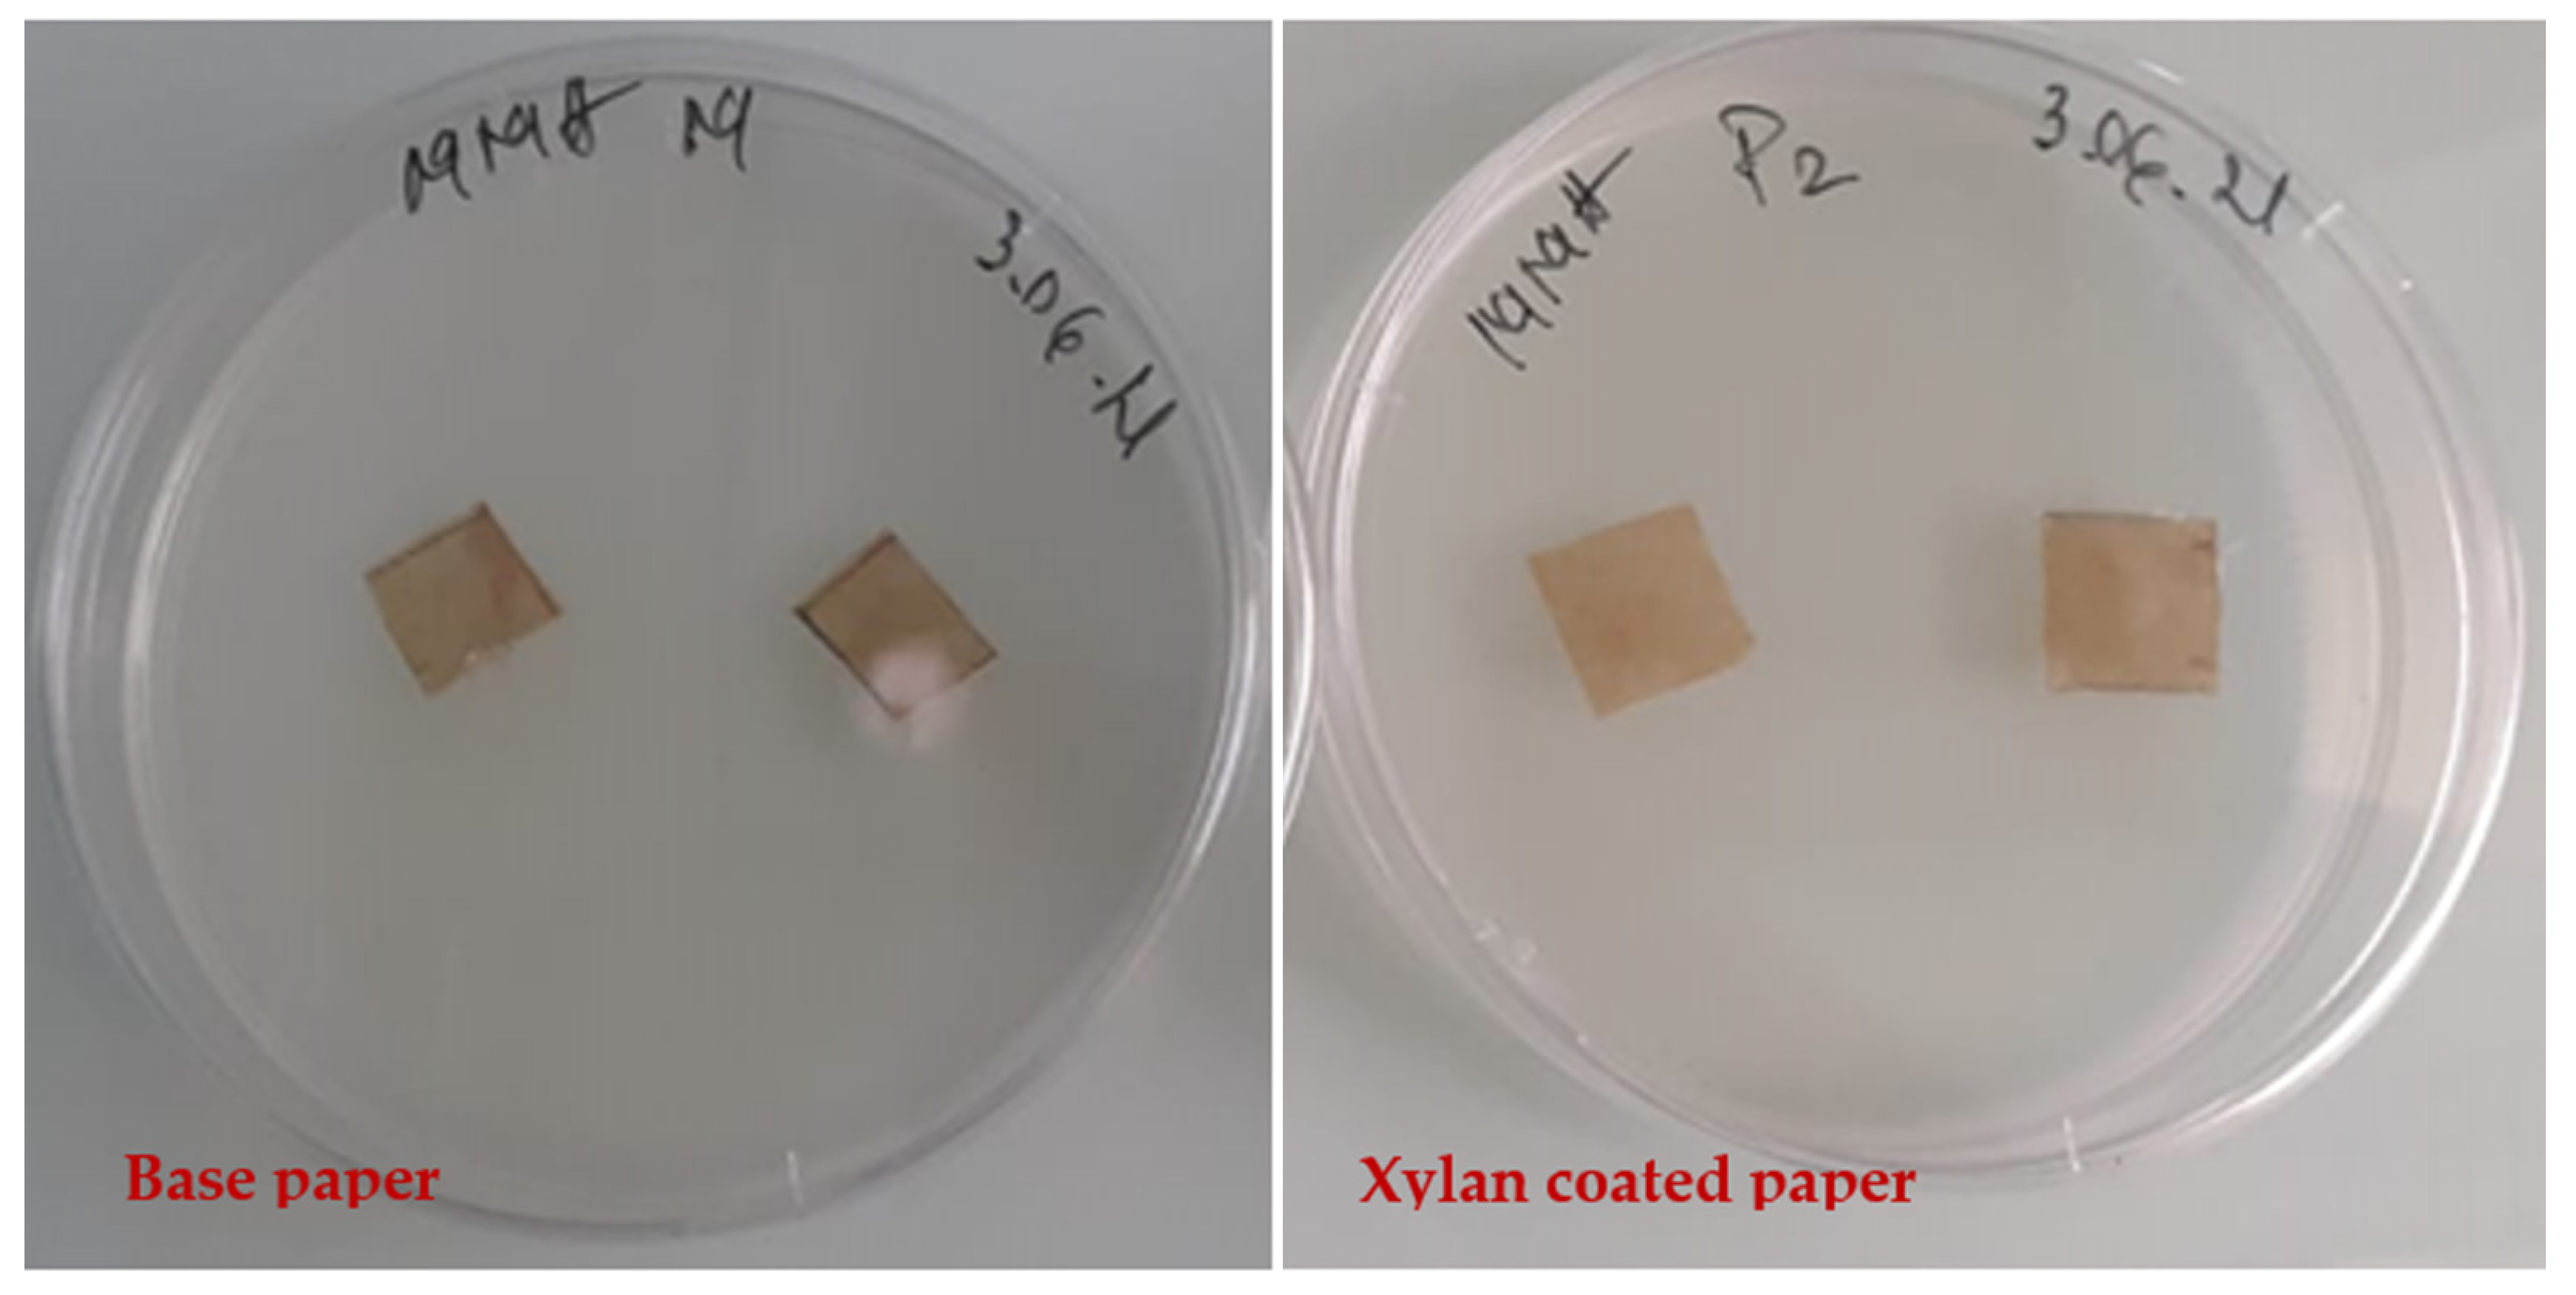
Sustainability 13 13504 g011

Xylan Hemicellulose: A Renewable Material with Potential Properties for Food Packaging Applications
Abstract
:1. Introduction
Xylan: A Major Type of Hemicelluloses
2. Materials and Methods
2.1. Materials
- Commercial base paper from unbleached cellulose pulp with a grammage of 50 g/m2 and water absorption, Cobb index of 28 g/m2;
- Xylan hemicellulose from beechwood—brown powder purchased from Carl Roth Company, Germany; it was used as an aqueous dispersion of 20 g/L;
- Chitosan, as fine particulate material, was purchased from the Vanson Company, with high molecular mass and degree of acetylation about 20.8%; it was used as dispersed in acetic acid (1%);
- Glycerol (plasticiser), as a pharmaceutical commercial product with 99% purity.
2.2. Methods
- Xylan Hemicellulose’s Characterisation
- Film Preparation
- Surface Treatments (Coating) of Paper
2.2.1. Testing Methods for Coated Paper Samples
- Air Permeability
- Water Absorption Capacity
- Oil Absorption Capacity
- Water Vapour Permeability (WVTR), g/m2.day
- Static Contact Angle (CA)
- Dry and Wet Tensile Strength
- Tearing Strength
- Bursting Strength
- Antimicrobial Activity
- Antifungal Activity
2.2.2. Testing Methods for Xylan Film Samples
3. Results and Discussions
3.1. FT IR Analysis of Xylan Biopolymer
3.2. Barrier Properties of Xylan-Coated Papers
3.3. Mechanical Strength Properties of Coated Paper Samples
3.4. Antimicrobial and Antifungal Activity of Coated Paper Samples
3.5. Film-Forming Ability of Xylan Hemicellulose and Water Barrier Properties of Films
4. Conclusions
Author Contributions
Funding
Institutional Review Board Statement
Informed Consent Statement
Data Availability Statement
Acknowledgments
Conflicts of Interest
References
- German Packaging Law 2019—New Obligations for Online Retailers in Germany. Available online: https://www.clickworker.com/2018/11/22/german-packaging-law-2019/ (accessed on 20 August 2021).
- Plastics Fact Sheet Global Action. Available online: https://ec.europa.eu/commission/sites/beta-political/files/plastics-factsheet-global-action_en.pdf (accessed on 22 September 2021).
- European Commission Releases a New Plastics Strategy. 19 January 2018. Available online: https://www.lexology.com/library/detail.aspx?g=af12a6e8-64ff-4cb6-9b09-266e72a6b7d4 (accessed on 22 September 2021).
- Wissam, F. Investigation of Hemicellulose Biomaterial Approaches: The Extraction and Modification of Hemicellulose and Its Use in Valueadded Applications. Ph.D. Thesis, L’Université de Lyon, Lyon, France, Université Jean Monnet Saint-Etienne, Saint-Étienne, France, North Carolina State University, Raleigh, NC, USA, 2018. [Google Scholar]
- Christopher, L. Adding Value Prior to Pulping: Bioproducts from Hemicellulose. In Global Perspectives on Sustainable Forest Management; Clement, A.O., Ed.; InTech: RijeKa, Croatia, 2012; ISBN 978-953-51-0569-5. [Google Scholar]
- Marchand, C. Design and Preparation of Films from Birchwood Xylan, Degree Project in Fibre and Polymer Technology KF200X.; Kth Royal Institute of Technology: Stockholm, Sweden, 2018. [Google Scholar]
- Hansen, N.M.L.; Plackett, D. Sustainable films and coatings from hemicelluloses: A review. Biomacromolecules 2008, 9, 1493–1505. [Google Scholar] [CrossRef] [PubMed]
- Ciolacu, D.E. Biochemical modification of lignocellulosic biomass. In Biomass as Renewable Raw Material to Obtain Bioproducts of High-Tech Value; Popa, V.I., Volf, I., Eds.; Elsevier: Amsterdam, The Netherlands, 2018; pp. 154–196. [Google Scholar]
- Menon, V.; Prakash, G.; Rao, M. Value added products from hemicellulose: Biotechnological perspective. Glob. J. Biochem. 2010, 1, 36–67. [Google Scholar]
- Ebringerova, A.; Hromadkova, Z.; Heinze, T. Hemicellulose. Adv. Polym. Sci. 2005, 186, 1–67. [Google Scholar] [CrossRef]
- Ren, J.L.; Sun., R.C. Hemicelluloses. In Cereal Straw as a Resource for Sustainable Biomaterials and Biofuels; Elsevier: Amsterdam, The Netherlands, 2010; pp. 150–300. [Google Scholar] [CrossRef]
- Geng, W.; Venditti, R.A.; Pawlak, J.J.; Chang, H.; Pal, L.; Ford, E. Carboxymethylation of hemicellulose isolated from poplar (Populus grandidentata) and its potential in water-soluble oxygen barrier films. Cellulose 2020, 21, 3359–3377. [Google Scholar] [CrossRef]
- Peng, X.; Du, F.; Zhong, L. Synthesis, Characterization, and Applications of Hemicelluloses Based Eco-friendly Polymer Composites. In Sustainable Polymer Composites and Nanocomposites; Inamuddin, S.T., Raghvendra, K.M., Asiri, A., Eds.; Springer: Berlin/Heidelberg, Germany, 2019; pp. 1267–1322. [Google Scholar]
- Rahman, M.L.; Sarkax, S.M.; Yusoff, M.M.; Abdullah, M.H. Optical detection and efficient removal of transition metal ions from water using poly (hydroxamic acid) ligand. J. Sens. Actuators B Chem. 2017, 242, 595–608. [Google Scholar] [CrossRef]
- Zhang, L.; Xue, W.; Gu, L. Modification of hyperbranched hemicellulose polymer and its application in adsorbing acid dyes. Cellulose 2019, 26, 5583–5601. [Google Scholar] [CrossRef]
- Qaseem, M.F.; Shaheen, H.; Wu, A.M. Cell wall hemicellulose for sustainable industrial utilization. Renew. Sustain. Energy Rev. 2021, 144, 110996. [Google Scholar] [CrossRef]
- Akubude, V.C.; Okafor, J.A.; Oyedokun, O.O.; Petinrin, K.N. Application of Hemicellulose in Biohydrogen Production. In Sustainable Bioconversion of Waste to Value Added Products; Inamuddin, A.K., Ed.; Springer: Berlin/Heidelberg, Germany, 2021; p. 254. [Google Scholar]
- Mikkonen, K.S.; Tenkanen, M. Sustainable food-packaging materials based on future biorefinery products: Xylans and mannans. Trends Food Sci. Tech. 2012, 28, 90. [Google Scholar] [CrossRef]
- Deutschmann, R.; Dekker, R.F.H. From plant biomass to bio-based chemicals: Latest developments in xylan research. Biotechnol. Adv. 2012, 30, 1627–1640. [Google Scholar] [CrossRef] [PubMed]
- Huang, Y.; Wang, Z.G.; Wang, L.S.; Chao, Y.S.; Akiyama, T.; Yokoyama, T.; Matsumoto, Y. Hemicellulose compostion in different cell wall fractions obtained using a DMSO/LiCl wood solvent system and enzyme hydrolysis. J. Wood. Chem. Technol. 2015, 36, 56–62. [Google Scholar] [CrossRef]
- Laine, C.; Asikainen, S.; Talja, R.; Stepan, A.; Sixta, H.; Harlin, A. Simultaneous bench scale production of dissolving grade pulp and valuable hemicelluloses from softwood kraft pulp by ionic liquid extraction. Carbohydr. Polym. 2016, 136, 402–408. [Google Scholar] [CrossRef]
- Li, Z.Q.; Qin, M.H.; Xu, C.L.; Chen, X.Q. Hot water extraction of hemicelluloses from aspen wood chips of different sizes. BioResources 2013, 8, 5690–5700. [Google Scholar] [CrossRef] [Green Version]
- Nechita, P.; Roman, M. Review on polysaccharides used in coatings for food packaging papers. Coatings 2020, 10, 566. [Google Scholar] [CrossRef]
- Placket, D. Biopolymers—New Materials for Sustainable Films Coatings; John Wiley & Sons Ltd.: Hoboken, NJ, USA, 2011; p. 252. [Google Scholar]
- Ebringerová, A.; Heinze, T. Xylan and xylan derivatives—Biopolymers with valuable properties, 1. Naturally occurring xylans structures, isolation procedures and properties. Macromol. Rapid Commun. 2000, 21, 542–556. [Google Scholar] [CrossRef]
- Yves, S.Y.; Philip, J.H. Xylans of Red and Green Algae: What Is Known about Their Structures and How They Are Synthesised? Polymers 2019, 11, 354. [Google Scholar] [CrossRef] [Green Version]
- Ramos, A.; Sousa, S.; Evtuguin, D.; Gamelas, J. Functionalized xylans in the production of xylan-coated paper laminates. React. Funct. Polym. 2017, 117, 89–96. [Google Scholar] [CrossRef]
- Broekaert, W.F.; Courtin, C.M.; Verbeke, C.; Van de Wiele, T.; Verstraete, W.; Delcour, J.A. Prebiotic and Other Health-Related Effects of Cereal-Derived Arabinoxylans, Arabinoxylan-Oligosaccharides, and Xylooligosaccharides. Crit. Rev. Food Sci. Nutr. 2011, 51, 178–194. [Google Scholar] [CrossRef] [PubMed]
- Petzold-Welcke, K.; Schwikal, K.; Daus, S.; Heinze, T. Xylan derivatives and their application potential—Mini-review of own results. Carbohydr. Polym. 2014, 100, 80–88. [Google Scholar] [CrossRef]
- Konduri, M.K.; Fatehi, P. Synthesis and characterization of carboxymethylated xylan and its application as a dispersant. Carbohydr. Polym. 2016, 146, 26–35. [Google Scholar] [CrossRef] [PubMed]
- Realini, C.E.; Marcos, B. Active and intelligent packaging systems for a modern society. Meat. Sci. 2014, 98, 404–419. [Google Scholar] [CrossRef] [Green Version]
- Hartman, J.; Albertsson, A.C.; Sjöberg, J. Surface- and bulk-modified galactoglucomannan hemicellulose films and film laminates for versatile oxygen barriers. Biomacromolecules 2006, 7, 1983–1989. [Google Scholar] [CrossRef] [PubMed]
- Wang, J.; Minami, E.; Kawamoto, H. Thermal reactivity of hemicellulose and cellulose in cedar and beech wood cell walls. J. Wood Sci. 2020, 66, 41. [Google Scholar] [CrossRef]
- Solier, Y.N.; Schnell, C.N.; Galván, M.V.; Mocchiutti, P.; Zanuttini, M.A.; Inalbon, M.C. Fast Preparation of Flexible Wet-Resistant and Biodegradable Films from a Stable Suspension of Xylan/Chitosan Polyelectrolyte Complexes. J. Polym. Environ. 2021. [Google Scholar] [CrossRef]
- Silva Braga, R.; Poletto, M. Preparation and Characterization of Hemicellulose Films from Sugarcane Bagasse. Materials 2020, 13, 941. [Google Scholar] [CrossRef] [Green Version]
- Nicu, R.; Lupei, M.; Balan, T.; Bobu, E. Alkyl–chitosan as paper coating material to improve water barrier properties. Cell Chem. Technol. 2013, 47, 623. [Google Scholar]
- Vartiainen, J.; Vähä-Nissi, M.; Harlin, A. Biopolymer Films and Coatings in Packaging Applications—A Review of Recent Developments. Mat. Sci. Appl. 2014, 5, 708. [Google Scholar] [CrossRef] [Green Version]
- Kesäläinen, S. Improving Plasticity and Film-Forming Quality of Xylans through Chemical Modification in Aqueous Phase. Master’s Thesis, Faculty of Science and Engineering, Abo Akademi University, Turku, Finland, 2020. [Google Scholar]
- Balan, T.; Guezennec, C.; Nicu, R.; Ciolacu, F.; Bobu, E. Improving Barrier and Strength Properties of Paper by Multi-Layer Coating with Bio-Based Additives. Cellul. Chem. Technol. 2015, 49, 607–615. [Google Scholar]
- Manea, D. Research Report of Project SAFEPACK-Special Packaging Materials from Cellulosic Fibers—A Viable Alternative for Foodstuffs Protection and Safety, Funded by Romanian National R&D Programm Contract No. 52—169/2008. Available online: http://www.ceprohart.ro/safepack.php (accessed on 20 October 2021).
- Anthony, R.; Xiang, Z.; Runge, T. Paper coating performance of hemicellulose-rich natural polymer from distiller’s grains. Prog. Org. Coat. 2015, 89, 240–245. [Google Scholar] [CrossRef] [Green Version]
- Laine, C.; Harlin, A.; Hartman, J.; Hyvarinen, S.; Kanmiovirta, K.; Krogerus, B.; Pajari, H.; Rautkoski, H.; Setala, H.; Sievanen, J.; et al. Hydroxyalkylated xylans—Their synthesis and application in coatings for packaging and paper. Ind. Crops Prod. 2013, 44, 692–704. [Google Scholar] [CrossRef]
- Zachary, W. An Investigation of the Efficacy of Corn Cob Hemicellulose as a Gas Barrier and Dry Strength Agent on Previously Uncoated Linerboard. Honors Thesis, Western Michigan University, Kalamazoo, MI, USA, 2018. Available online: https://scholarworks.wmich.edu/honors_theses/3010 (accessed on 1 October 2021).
- Ruoxi, A.P.; Fleming, P.; Husovska, V. Preparation and characterization of hemicellulose-based printable films. Cellul. Chem. Technol. 2017, 51, 939–948. [Google Scholar]
- Wang, F.; Wang, L.; Zhang, X.; Ma, S. Improved Oil Resistance of Cellulose Packaging Paper by 1 Coating with Natural Polymer Derived Materials. 2021. Available online: https://www.researchsquare.com/article/rs-306787/v1.pdf (accessed on 1 October 2021).
- Bobu, E.L.; Nicu, R.A.; Obrocea, P.; Ardelean, E.L.; Dunca, S.; Balaes, T. Antimicrobial properties of coatings based on chitosan derivatives for applications in sustainable paper conservation. Cellul. Chem. Technol. 2016, 50, 689–699. [Google Scholar]
- Nechita, P.; Bobu, E.; Parfene, G.; Dinică, R.M.; Bălan, T. Antimicrobial coatings based on chitosan derivatives and quaternary ammonium salts for packaging paper applications. Cellul. Chem. Technol. 2015, 49, 625–632. [Google Scholar]
- Yang, Y.C.; Mei, X.W.; Hu, Y.J.; Su, L.Y.; Bian, J.; Li, M.F.; Peng, F.; Sun, R.C. Fabrication of antimicrobial composite films based on xylan frompulping process for food packaging. Int. J. Biol. Macromol. 2019, 134, 122–130. [Google Scholar] [CrossRef]
- Xu, G.; Luo, Y.; Song, T.; He, B.; Chang, M.; Ren, J. Xylan based antibacterial additive. BioResources 2020, 15, 4781–4801. [Google Scholar] [CrossRef]
- Fu, G.-Q.; Zhang, S.-C.; Chen, G.-G.; Hao, X.; Bian, J.; Peng, F. Xylan-based hydrogels for potential skin care application. Int. J. Biol. Macromol. 2020, 158, 244–250. [Google Scholar] [CrossRef] [PubMed]
- Lobo, F.; Franco, A.R.; Fernandes, E.M.; Reis, R.L. An Overview of the Antimicrobial Properties of Lignocellulosic Materials. Molecules 2021, 26, 1749. [Google Scholar] [CrossRef]

| Composition | Sample Code |
|---|---|
| Xylan | XHc |
| Xylan and glycerol (25%) | XG |
| Xylan with ethanol solvent | XP1/25 |
| Xylan:chitosan ratio 50:50 | 50XCh |
| Xylan:chitosan ratio 70:30 | 70XCh |
| Xylan:chitosan ratio 80:20 | 80XCh |
| Region/Area, cm−1 | Stretching Vibration | Class of Potential Functional Groups |
|---|---|---|
| 1000–1200 | νC-H-O/νC-OH | esters/ethers |
| 3000–3700 | alcohols | |
| ~3410 | νCO-H | aldehydes |
| 2800–3050 | νC-H | -CH3,-CH2,-CH |
| 1460 | ν-COCH3 | acetyl l |
| 2839 | ν-CH2 | metoxi |
| 2856 | ν-CH3 | C-CH3 |
| 1725–1737 | νc=o | aldehyde/ketone groups |
| 1414 | νcoo- | carboxylic acids |
| 894 | 1–4 glycosidic bond between xylopyranose units | xylanic chains |
| Property | Base Paper | Xylan Coated Paper |
|---|---|---|
| Air permeability, Gurley, s | 89.95 | 167.1 |
| Water vapours transmission rate, g/m2/day | 233.3 | 211.63 |
| Property | Base Paper | Xylan Coated Paper |
|---|---|---|
| Tearing strength, mN | 480 | 440 |
| Bursting strength, kPa | 200 | 279 |
| Sample | Swelling Capacity, % | Solubility, % |
|---|---|---|
| 50XCh | 73.2 | 78.3 |
| 70XCh | 85.4 | 82.4 |
| 80XCh | 90.0 | 95.5 |
| XHc | 94.2 | 99.23 |
| XG | 93.2 | 98.9 |
| XP1/25 (alcohol) | 93.5 | 99.25 |
Publisher’s Note: MDPI stays neutral with regard to jurisdictional claims in published maps and institutional affiliations. |
© 2021 by the authors. Licensee MDPI, Basel, Switzerland. This article is an open access article distributed under the terms and conditions of the Creative Commons Attribution (CC BY) license (https://creativecommons.org/licenses/by/4.0/).
Share and Cite
Nechita, P.; Mirela, R.; Ciolacu, F. Xylan Hemicellulose: A Renewable Material with Potential Properties for Food Packaging Applications. Sustainability 2021, 13, 13504. https://doi.org/10.3390/su132413504
Nechita P, Mirela R, Ciolacu F. Xylan Hemicellulose: A Renewable Material with Potential Properties for Food Packaging Applications. Sustainability. 2021; 13(24):13504. https://doi.org/10.3390/su132413504
Chicago/Turabian StyleNechita, Petronela, Roman Mirela, and Florin Ciolacu. 2021. "Xylan Hemicellulose: A Renewable Material with Potential Properties for Food Packaging Applications" Sustainability 13, no. 24: 13504. https://doi.org/10.3390/su132413504
APA StyleNechita, P., Mirela, R., & Ciolacu, F. (2021). Xylan Hemicellulose: A Renewable Material with Potential Properties for Food Packaging Applications. Sustainability, 13(24), 13504. https://doi.org/10.3390/su132413504

